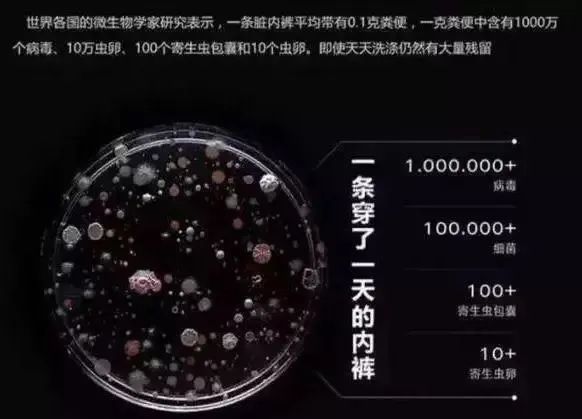

女人的内裤不仅是御体遮羞,犹如第二层肌肤,一条清爽透气、抑菌、亲肤的内裤,会让小妹妹自由呼吸,也让私处无异味、更干净。

穿错了内裤,很容易惹祸上身,现在很多人选内裤,只图一时便宜,在乎价格,忽视内裤的布料和杀菌效果。
穿上像是绑在身上一样,闷热,不透气,热得如同火炉一样,异味难闻,还时不时瘙痒,容易变形,洗完以后又黄又硬。

内裤一穿就是一天,甚至有人穿三天、一周……下面的异味如果不及时处理,滋养各种细菌,是导致妇科疾病的罪魁祸首。
相关数据也表明,内裤穿一天,就会产生0.1g粪便,10万个细菌、100万个病毒,1000个寄生虫包囊!
世界卫生组织发出警告,女性80%的妇科疾病反复发作,很大程度上与内裤有关!你平时选的内裤,可能都不适合、不健康。

内裤选得好,私处才能保养老,一条好的内裤穿在身上,如腾云驾雾一样、能够自由呼吸,一整天不闷不燥,清爽无比,小妹妹的快乐又回来了!

小编作为一个内裤党,试穿太多内裤,对好内裤深有感触,一款好的内裤必须要,透气、清爽、抑菌、又贴肤。
没错了,就是这款内裤,堪称"内裤里的爱马仕",亲肤好*压花设计,无紧绷,透气导湿,远离各种妇科疾病!

进口德绒发热纤维,运用干纺超细异型戳面技术,使面料蓬松度高于其他同类型纤维,更能有效持续锁定热量。


10s去异味,根源守护私处
内裤作为私处的护身符,她的质量,直接决定了私处的健康,秋季闷热,容易滋生细菌,各种看不见的细菌,活跃在内裤上,引发各种妇科病。
传统的内裤,抑菌不明显,化学添加剂多,对身体也有害,底裆容易潮湿,臭气熏天,穿完一天后,松垮又黄、又硬。

这款内裤采用全新的抗菌科技德绒面料,提取高浓度纤维,抑菌率高。
采用创新的萃取技术,以艾草为原料,精制提炼后,经过去除,溶解,过滤等步骤,最后得到天然的海藻纤维。

其中的艾草纤维对付,大肠杆菌、金黄色葡萄球菌等细菌,360°全面扫射,24小时抑菌,即便在内裤的边边角角,也能全部秒杀掉,保持内裤干净。

权威机构检测,抑菌率高,抑菌效果达到 AAA 级别。

穿之前细菌密集程度90%,穿上海藻内裤后,内裤上的菌落群明显减少,肉眼可见,所剩无几,抑菌效果超级给力!

平时工作,一坐就是一整天,很多女性的内裤,下面闷热、潮湿不透气,天气热时,异味发酵更难闻,穿上这款海藻内裤,再也不担心小妹妹被闷坏了,一天到晚下面清凉、透气,既清爽又干净,更没有细菌的滋生。

高弹力舒适,穿出蜜桃臀
内裤作为贴身的衣服,不仅要抑菌,更要亲肤、透气,不要为了便宜,或者图省事,买不透气、布料差的内裤。相比普通内裤,这款内裤,打破传统内裤的不透气、粗糙,选用德绒,穿起来,有种德芙般的丝滑,摸像穿了皮肤一样舒服,还能自由呼吸。

透气又干爽,是面料中zui舒服的,集温柔的纤维、棉的柔软,丝的光泽、麻的清爽于一体,穿在身上顺滑、干爽,透气性非常好。

相比普通的面料,这款德绒,做工精细,天然环保原料,柔软性更好、成本高。经过严格的工序,制作成木浆,亲肤、穿在身上透气性好。

添加10%的氨纶布料,有弹性,即使你是XXL的腰围,也能穿上M型号,氨纶具有高回弹力和纤维记忆力,轻松拉出3倍的弹力效果,具有很大的包容性。如丝绸般柔软、爽滑,穿身在上,有披着棉花的云雾感,犹如肌肤般丝滑,内裤弹力大,穿个一年半载,内裤也不会不变形。

即便运动完后,全身大汗淋漓,内裤内裆也不会潮湿,吸汗的同时,还能抑制细菌,穿上柔软、舒服,透气凉爽一整天。

3D剪裁,细节设计
包臀不夹臀,独立包装
这款内裤,采用3D剪裁技术,穿上之后,立显翘臀,无勒痕,360度无缝养护,穿之前和穿之后,有明显对比。

使用无感的标签 ,刺痒不硌人,消灭了令人刺痒的缝制标签,杜绝了化学品直接瘙痒,它是每条内物的寿命指示标。



穿着少女感的内裤,立显翘臀,看起来非常性感,走在街上或者运动,既性感又飒,不仅让男性蠢蠢欲动,就连女性同胞们也羡慕不已。

这款内裤集抑菌、清爽、透气、亲肤为一体,犹如女人的生命线,长久相伴,不仅让私处永葆健康,还能向老公,散发出柔软的魅力。

粉丝福利价:75元/4条
